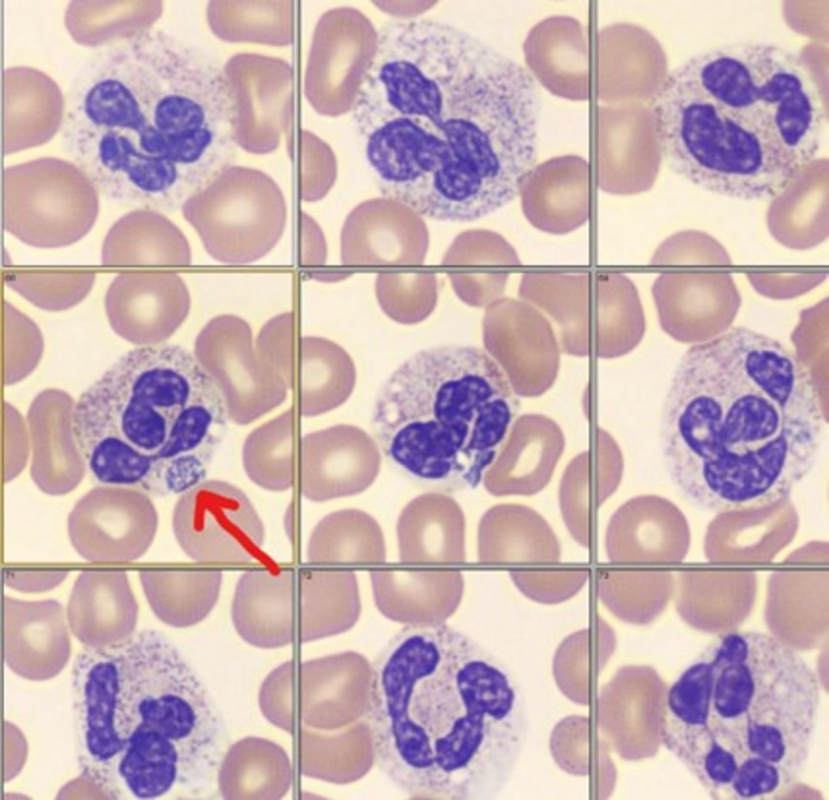

Женщина 70 лет поступила в больницу с жалобами на лихорадку, ригидность, слабость, головную боль и головокружение в течение 6 дней; в анамнезе у нее астма, диабет 2 типа, тахикардия.
За 5 дней до нынешнего визита пациентка также наблюдалась у врача по поводу болей в животе, тошноты и лихорадки. Боль в животе прошла, но у пациентки пропал аппетит. Она призналась, что перед этим визитом спала в постели со своей собакой. Ни при одном посещении не было отмечено склерального иктерита, сыпи, кашля, жжения в мочевыводящих путях или ригидности шеи.
Были назначены компьютерная томография, анализ функции печени, коагулограмма, культура крови и анализы крови на паразитов. В анализе крови были отмечены следующие клетки (рис. 1).
Рисунок 1. Морулы внутри нейтрофила.
Обсуждение
Круглые светло-фиолетовые пятна, на которые указывает стрелка на рисунке, являются морулами, свидетельствующими о Anaplasma phagocytophilum, возбудителе "гранулоцитарного анаплазмоза человека (ГАЧ)". ГАЧ - это клещевое заболевание и число случаев заболевания в последние годы постоянно растет. Первые симптомы после укуса клеща обычно проявляется примерно через неделю после укуса. Ранняя диагностика на начальной стадии может быть затруднена, поскольку лабораторные серологические тесты часто дают отрицательные результаты на антитела.
Необходимо тщательно изучить клинические признаки и симптомы, историю поездок, активность на открытом воздухе и контакты с животными. ПЦР является наиболее чувствительным и специфичным методом диагностики. Для подтверждения морфологии паразита можно сделать мазок крови, хотя у пациентов может наблюдаться лейкопения, приводящая к снижению чувствительности.
В данном случае результаты лабораторных исследований показали критическую гипонатриемию (121 ммоль/л) и тромбоцитопению (33 K/uL). Пациентка была госпитализирована в отделение и ей был назначен 10-дневный курс доксициклина. Крайняя гипонатриемия, связанная с анаплазмозом, встречается нечасто, и механизм ее возникновения неясен; однако все зарегистрированные случаи подходят под описание SIADH - синдрома неадекватной секреции антидиуретического гормона (Ladzinski et al., 2021).
От редактора:
В России первые данные об этом заболевании появились в 2002 году. На территории нашей страны ГАЧ выявляют практически повсеместно: Горном Алтае, Иркутской области,
на Дальнем Востоке, Тюменской области, Омской и Томской, Воронежской, Тульской областях, в Красноярском крае и многих других территориях.
С января 2013 года приказом Росстата РФ от 20.12.2012 № 645 утверждена статистическая отчетность по форме № 1 дополнительно по ГАЧ. За 2016 год в Российской Федерации было выявлено 53 случая ГАЧ. C 16 марта 2017 года во всех федеральных округах России проводится еженедельный мониторинг за инфекциями, передающимися клещами, в том числе ГАЧ. За неполный 2017 год сообщено о 21 случае ГАЧ в России.